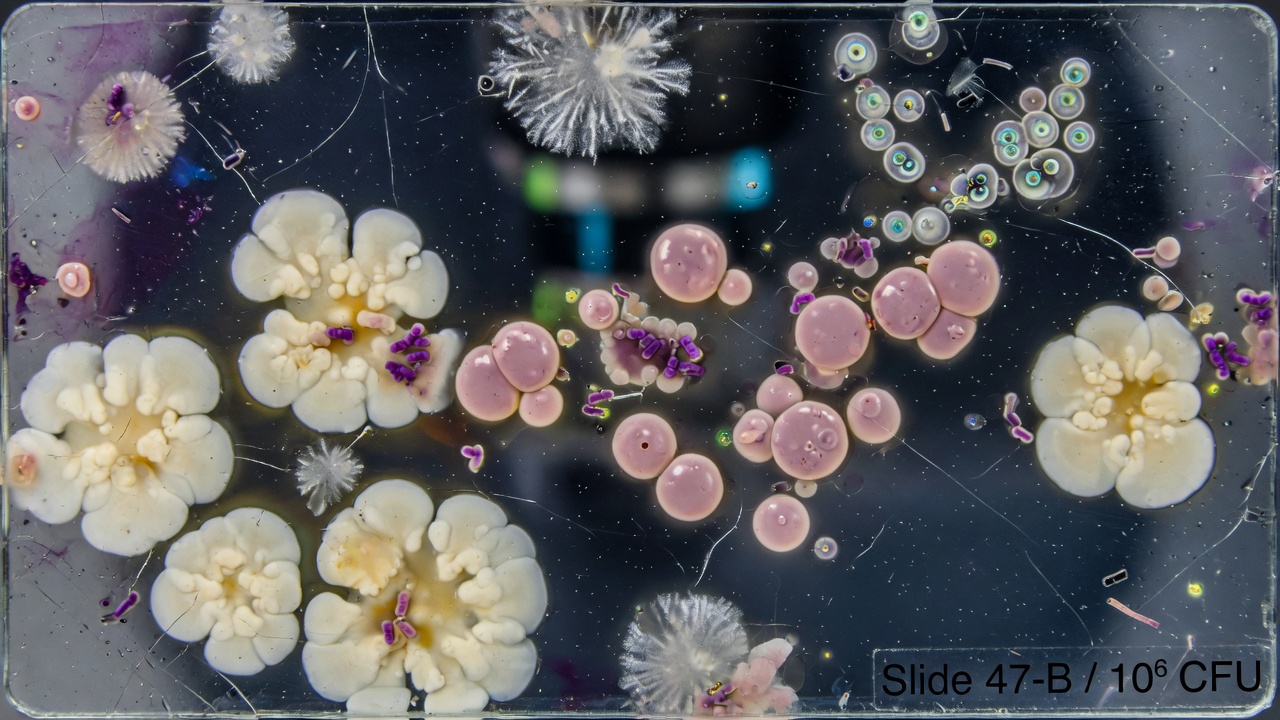

Une infection touche 1 milliard de femmes, reclassée comme IST dans plusieurs pays
Auteur: Simon Kabbaj
Une affection intime aussi répandue que méconnue
Chlamydia, gonorrhée, syphilis ou encore papillomavirus humain (HPV). Quand on évoque les infections sexuellement transmissibles (IST), ces noms viennent immédiatement à l’esprit. Pourtant, une autre infection intime, bien moins connue du grand public, affecte plus d’un milliard de femmes chaque année à travers le monde. Rien qu’au Royaume-Uni, plus d’un tiers de la population féminine y est confrontée au moins une fois dans sa vie.
Son nom : la vaginose bactérienne (VB). Il ne s’agit pas techniquement d’une IST selon les classifications actuelles dans certains pays, mais d’une pathologie très courante provoquée par un déséquilibre de la flore bactérienne naturelle du vagin. Cependant, compte tenu de son mode de transmission et de son impact, de plus en plus de voix s’élèvent pour qu’elle soit enfin reconnue comme une infection sexuellement transmissible à part entière.
Qu’est-ce que la vaginose bactérienne et quels sont ses symptômes ?

La vaginose bactérienne est le résultat d’un changement dans l’équilibre naturel des micro-organismes présents dans le vagin. Dans de nombreux cas, elle est considérée comme un risque lié à une vie sexuelle active ou au changement de partenaire. Mais cela ne signifie pas que ses manifestations doivent être ignorées ou minimisées. Les symptômes sont souvent très inconfortables et peuvent alerter les patientes.
Parmi les signes les plus courants, on retrouve des pertes vaginales inhabituelles, une forte odeur de poisson provenant de la zone génitale, des démangeaisons ou une irritation locale, ainsi qu’une sensation de brûlure lors de la miction. Un autre fait important à noter est que les bactéries responsables de la VB chez la femme peuvent être transportées par les hommes, même si ces derniers ne possèdent pas de vagin et ne développent pas de symptômes.
L’appel au changement : « La preuve la plus solide à ce jour »

Face à la détresse physique et psychologique que peut engendrer la vaginose bactérienne, et considérant qu’elle découle souvent de rapports sexuels, des militants de la santé sexuelle plaident pour sa reclassification en tant qu’IST. Parmi eux, Valentina Milanova, gynécologue et fondatrice de la marque de santé gynécologique Daye. Interrogée par le journal Metro, elle insiste sur l’urgence pour les autorités sanitaires et éducatives britanniques de mettre à jour leurs recommandations.
« L’argument traditionnel contre le fait de qualifier la vaginose bactérienne d’IST est qu’elle provient d’une prolifération de la flore endogène plutôt que d’un pathogène externe unique, mais cela devient de plus en plus difficile à défendre », explique-t-elle. Pour appuyer son propos, Valentina Milanova cite un essai publié dans le New England Journal of Medicine en 2025, qui a démontré que les taux de guérison s’amélioraient de manière spectaculaire lorsque les partenaires masculins étaient traités en même temps que leur partenaire féminine.
Elle poursuit : « Cela fournit la preuve la plus solide à ce jour que la VB est sexuellement transmissible et que la réinfection est un facteur principal de son taux de récidive notoirement élevé, qui peut atteindre jusqu’à 50 % en six mois ».
Le Royaume-Uni à la traîne, des recommandations dépassées ?

La question de la classification de la vaginose bactérienne ne fait pas débat partout. De l’autre côté de l’Atlantique, aux États-Unis, ainsi qu’au Canada et en Australie, elle est déjà catégorisée comme une IST. C’est également le cas au sein de l’Organisation Mondiale de la Santé (OMS). Alors, pourquoi le Royaume-Uni hésite-t-il ? La réponse est simple : les directives de l’Association britannique pour la santé sexuelle et le VIH (British Association for Sexual Health and HIV) n’ont pas été mises à jour depuis 14 ans.
Cette situation a des conséquences concrètes sur la prise en charge des patientes. « En conséquence, les cliniciens ne traitent pas systématiquement les partenaires, n’avisent pas les contacts ou ne procèdent pas à un dépistage systématique — laissant de nombreuses femmes coincées dans un cycle de récidive qui affecte leur bien-être global », ajoute Valentina Milanova.
Une « dysbiose sexuellement associée » : une vision plus nuancée

Pour défendre la position actuelle, le Dr Giuseppe Aragona, médecin généraliste et conseiller médical, a apporté une perspective différente au média britannique. Selon lui, une éventuelle reclassification dépend de « la rigueur avec laquelle on définit » les IST. Il avance un argument technique : « Bien qu’il y ait de plus en plus de preuves de la dynamique de transmission sexuelle et de l’implication du partenaire dans la récidive, elle ne se comporte toujours pas comme une IST classique en termes d’organisme causal unique ou de mode de transmission simple ».
Pour le Dr Aragona, la classification la plus appropriée pour la vaginose bactérienne serait celle de « dysbiose sexuellement associée », un terme qui met l’accent sur le déséquilibre bactérien qui définit la maladie. Il concède néanmoins le bien-fondé de la démarche de ses confrères. « Mais je peux comprendre pourquoi certains cliniciens soutiennent que reconnaître plus explicitement sa transmissibilité sexuelle pourrait améliorer les stratégies de prévention et la gestion des partenaires », conclut-il.
Créé par des humains, assisté par IA.